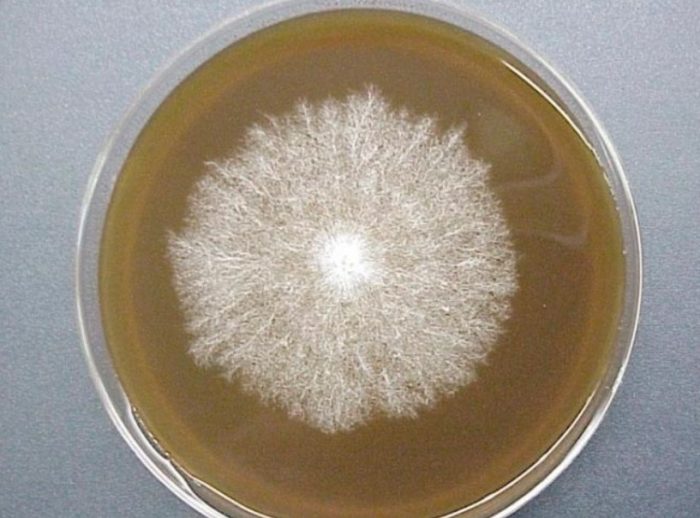
Споров метод за култивиране на мицел

Шампиньоните са едни от най-популярните гъби за домашно отглеждане. Мицелът може да се закупи от всеки специализиран магазин, но за да избегнете ненужни разходи, можете да си го направите сами у дома. За да направите това, трябва да спазвате правилната техника и да бъдете внимателни, когато работите с него, и вашият мицел ще бъде също толкова добър, колкото купен от магазина. Тази статия ще обясни как.
Съдържание
- 1 Как изглежда мицелът на шампиньона?
- 2 Методи за получаване на мицел от шампиньон
- 3 Подготовка на място за отглеждане на мицел от шампиньон у дома
- 4 Подготовка на контейнер за отглеждане на мицел от шампиньон у дома
- 5 Хранителна среда за отглеждане на мицел от шампиньон
- 6 Засяване на спори на мицел или шампиньон в хранителна среда
- 7 По-нататъшно размножаване на мицел от шампиньон
Как изглежда мицелът на шампиньона?
Мицелът на гъбите се отглежда в специален субстрат и изглежда като пухкав бял филм, който покрива изцяло субстрата. При висококачествения мицел ясно се виждат тънки бели нишки – частта от мицела, която обикновено е скрита под земята и е отговорна за храненето и размножаването.
Методи за получаване на мицел от шампиньон
Има два основни метода за производство на мицел: тъканна култура и спорова култура. Последният е по-сложен и изисква специална стерилност и грижи; най-често се използва в лабораторни условия.
Спори
Френски учени се считат за пионери на споровия метод за производство на мицел. Ако поставите зряла шапка с лицето надолу върху чист лист хартия, след известно време ще забележите разминаващи се линии. Това са спорите. Те обаче бързо умират във въздуха и са силно податливи на патогенни микроорганизми в околната среда. Затова в лабораториите спорите се засяват при стерилни условия директно в петриева паничка. След като мицелът започне да покълва, той се инокулира в специализиран субстрат.
Начин за производство на спори от шампиньон у дома
За да получим спори от шампиньон у дома, ще ни е необходимо следното оборудване:
- остър нож;
- целофанова торбичка;
- железен капак;
- спринцовка;
- дестилирана вода;
- клечка за зъби;
- 50 г стек;
- алкохол за дезинфекция.
Преди започване на работа дезинфекцирайте масата и цялото оборудване, за да предотвратите бактериално замърсяване. Торбата се дезинфекцира отвън и след това се обръща наопаки. Тя ще се използва за съхранение на контейнера със спорите.
Следващата стъпка е да вземете гъбата и внимателно да отстраните дръжката с нож, като подрежете извитите краища на шапката. Целият този процес също се извършва с обучени ръце.
Капачката се поставя върху капака, с хрилете надолу, и се притиска леко. След това цялата конструкция се опакова в торбичка, завързва се плътно и се съхранява на тъмно място за 2-4 дни.
След определеното време, върху капаците трябва да се появи отпечатък от спорите на гъбичките, подобен на ръждиво-кафяви ивици.
С помощта на спринцовка налейте малко количество вода в чаша за шот, предварително избърсана със спирт. Внимателно поставете спорите в чашата и ги изстържете с клечка за зъби.
След това изтеглете вода и спори в спринцовката, прикрепете иглата и затворете спринцовката. Суспензията от спори е готова. Тя може веднага да се постави в хранителната среда или да се съхранява в хладилник.
Разпознахте ли печурките от видеото? Да, разпознахте ги. Кралски печурки.
Плат
Това е един от първите методи за получаване на мицел, който е бил широко използван преди откриването на споровия метод.
Този метод включва поставяне на парче гъбена тъкан в стерилна хранителна среда. Най-добре е материалът да се вземе от центъра на плодното тяло, тъй като на повърхността може да има бактерии. Този метод е по-удобен за отглеждане на гъби у дома, но добивът от този вид мицел ще бъде малко по-нисък.
Подготовка на място за отглеждане на мицел от шампиньон у дома
Най-важното изискване за домашна среда за отглеждане на мицел е абсолютната стерилност. Всичко - от дрехи до съдове и самата стая - трябва да бъде дезинфекцирано. Масата, където ще се извършва работата, трябва да бъде покрита със стъкло и дезинфекцирана с алкохол.
Подготовка на контейнер за отглеждане на мицел от шампиньон у дома
Контейнерът за отглеждане на мицел трябва да е устойчив на топлина, за да може да се стерилизира добре.
Вкъщи използвайте епруветки с винтови капачки и стъклени буркани с отвор в центъра на капака. Всички те могат да се стерилизират в автоклав или тенджера под налягане, ако няма друго подходящо оборудване.
За промишлено производство се използват големи полиетиленови торби, като от вътрешната страна е залепен специален филтриращ материал, който предотвратява проникването на бактерии. В торбите се пробиват малки отвори, за да се осигури циркулация на въздуха.
Хранителна среда за отглеждане на мицел от шампиньон
За приготвяне на хранителна среда у дома е най-добре да се използва агар-агар, вещество, синтезирано от бели водорасли. Той позволява чужди микроорганизми да се видят на повърхността и лесно да се отстранят. Обикновено за култивиране на мицел се използват морковен, овесен, глюкозо-картофен или пивна агар.
Агар-агар с пивна мъст
Технология на готвене:
- Добавете 20 г агар-агар към 1 литър бирена мъст при стайна температура и разбъркайте.
- Поставете съда на слаб огън и гответе, докато се получи еднородна консистенция.
- Стерилизирайте епруветките и ги напълнете с агар-агар, използвайки стерилна фуния.
- Покрийте с памучен тампон и стерилизирайте за 30 минути на 101 градуса.
За да се увеличи повърхността на хранителната среда, епруветките могат да се наклонят след приготвяне, но агар-агарът не трябва да достига капака с няколко сантиметра.
Овесен агар
Овесеният агар се приготвя, както следва:
- 30 г овесено брашно се смесва с 15 г агар-агар.
- Прахът се разрежда в 970 мл вода.
- Съдът се поставя на слаб огън и сместа се готви 60 минути, като се разбърква редовно.
- Попарете марлята с вряла вода, сгънете я на няколко слоя и прецедете отварата през нея.
- Напълнете стерилен контейнер с агар-агар, като го наклоните под лек ъгъл.
Морковен агар
За да приготвите морковена агар-агар, пригответе 400 мл екстракт от моркови. Смесете 2 части настърган морков с 5 части вода и варете 30 минути, след което прецедете.
След това смесете екстракта от моркови, 600 мл вода и 15% агар-агар. Варете сместа 30 минути, като бъркате непрекъснато, след което прецедете през стерилна тензух.
Засяване на спори на мицел или шампиньон в хранителна среда
След като агар-агарът в епруветката се втвърди, можете да започнете да инокулирате спорите на гъбите. За целта отрежете малко парче от стъблото на гъбата с остро, стерилно острие. Можете също да използвате пинсети или специална стоманена игла с извит връх. Потопете получената тъкан в разтвор на водороден прекис за 1 секунда, за да я дезинфекцирате. След това бързо я поставете в епруветка, която бързо се затваря със стерилна капачка. За да се избегне замърсяване, всички стъпки трябва да се извършват над пламък на горелка.
След засаждането на спорите, епруветките се поставят на топло и тъмно място за две седмици. През това време, ако се спазват инструкциите за засаждане, мицелът ще запълни хранителната среда в епруветката. Този субстрат се нарича запасна култура. При постоянна температура той може да се съхранява дълго време и да се използва за пресаждане в нова хранителна среда.
По-нататъшно размножаване на мицел от шампиньон
И така, използвайки агар-агар и спори, получихме изходен материал, който след това използваме за размножаване на мицел у дома. Процедурата ще бъде следната:
- Стерилни трилитрови буркани се пълнят до 2/3 със субстрат, в който се прави вдлъбнатина за майчината култура.
- Бурканът се запечатва с плътно прилепващ метален капак, предварително стерилизиран. В капака трябва да се направи отвор, който се затваря плътно със стерилна запушалка.
- Приготвените буркани се поставят в автоклав с налягане от 2 атмосфери и се стерилизират в продължение на 2 часа.
- След стерилизацията те се поставят в дезинфекцирано помещение, за да се охладят.
- Когато температурата достигне 24 градуса, можете да започнете да добавяте основния материал.
Върху компост
Има много начини за готвене компост за печурки, но класическият компост се счита за този, направен от конски тор, птичи изпражнения и слама.
- Преди да поставите компоста в буркани, той трябва леко да се затопли до температура от 24 градуса.
- Напълнете контейнера на 2/3, затворете го с капак с отвор, в който се поставя коркова тапа.
- Стерилизирайте контейнерите в автоклав, след което добавете посевния материал от епруветките.
- Затворете плътно капака и го поставете на тъмно място.
Такъв мицел няма да се характеризира с високи добиви и дълъг срок на годност.
Как сами да отглеждате гъби Прочетете на нашия уебсайт.
На зърното
За зърнен мицел най-често се използват овес или пшеница, но ръж или ечемик също ще свършат работа.
Процедурата се извършва на следните етапи:
- Залейте зърното с вода в съотношение 2:3, добавете водороден прекис (1:10) и оставете да къкри 30 минути. Зърното не трябва да се разпада; трябва да е меко, но все пак да запази твърдата си структура.
- Отцедете водата, добавете малко гипс и тебешир към зърното, за да регулирате нивото на киселинност, поставете всичко върху метална мрежа и я поставете върху дървена кутия с прикрепен над нея вентилатор.
- Когато зърното изсъхне, то се прехвърля в буркан, като се пълни с 2/3 от обема му, стерилизира се с помощта на автоклав, добавя се майчината култура и се поставя на място с 60% влажност и температура 24 градуса.
- Ако по време на съхранение в буркана се появят зелени или кафяви петна, той трябва да се стерилизира отново за 2 часа.
- За да се предотврати слепването на зърната и да се осигури нормално развитие на мицела, бурканът се разклаща периодично.
- Приготвеният мицел може да се опакова в стерилни торбички, където може да се съхранява до 2 месеца при температура 0-2 градуса.
Върху картон
Използването на картон за отглеждане на мицел има редица предимства:
- Спестява време и разходи за труд.
- Рискът от излагане на патогенни микроорганизми е намален.
- Картонът задържа добре влагата.
- Гофрираната структура осигурява необходимата циркулация на въздуха.
- Материалът е евтин и достъпен.
- Няма нужда от стерилизиране на материала.
Етапи на отглеждане на мицел върху картон:
- Нарежете картона на малки парченца, накиснете ги във вряща вода на стайна температура за час и половина и ги поставете в пластмасов контейнер с дупки на дъното.
- Разделете гъбата на влакна с помощта на стерилно острие.
- Отлепете горната част на картона, разкривайки гофрираната повърхност.
- След като потопите парчетата гъби във водороден прекис, бързо ги поставете върху картон и покрийте с отстранения слой хартия, като леко ги уплътните, за да отстраните излишния въздух.
- Покрийте контейнера с торбичка или фолио.
- Премахвайте капака ежедневно, за да проветрите мицела.
- За да се предотврати изсъхването на картона, той трябва периодично да се навлажнява с топла вода.
- Поставете контейнера на тъмно място и го оставете там, докато цялата картонена повърхност се покрие с бял пух – растящият мицел. Това може да отнеме до три месеца.
Този мицел може да се използва за засаждане на мицел или може да се засади върху следващия лист картон, за да се увеличи обемът на материала.
А, знаеш това отглеждайте шампиньони в оранжерия във вашата вила Не е чак толкова трудно.